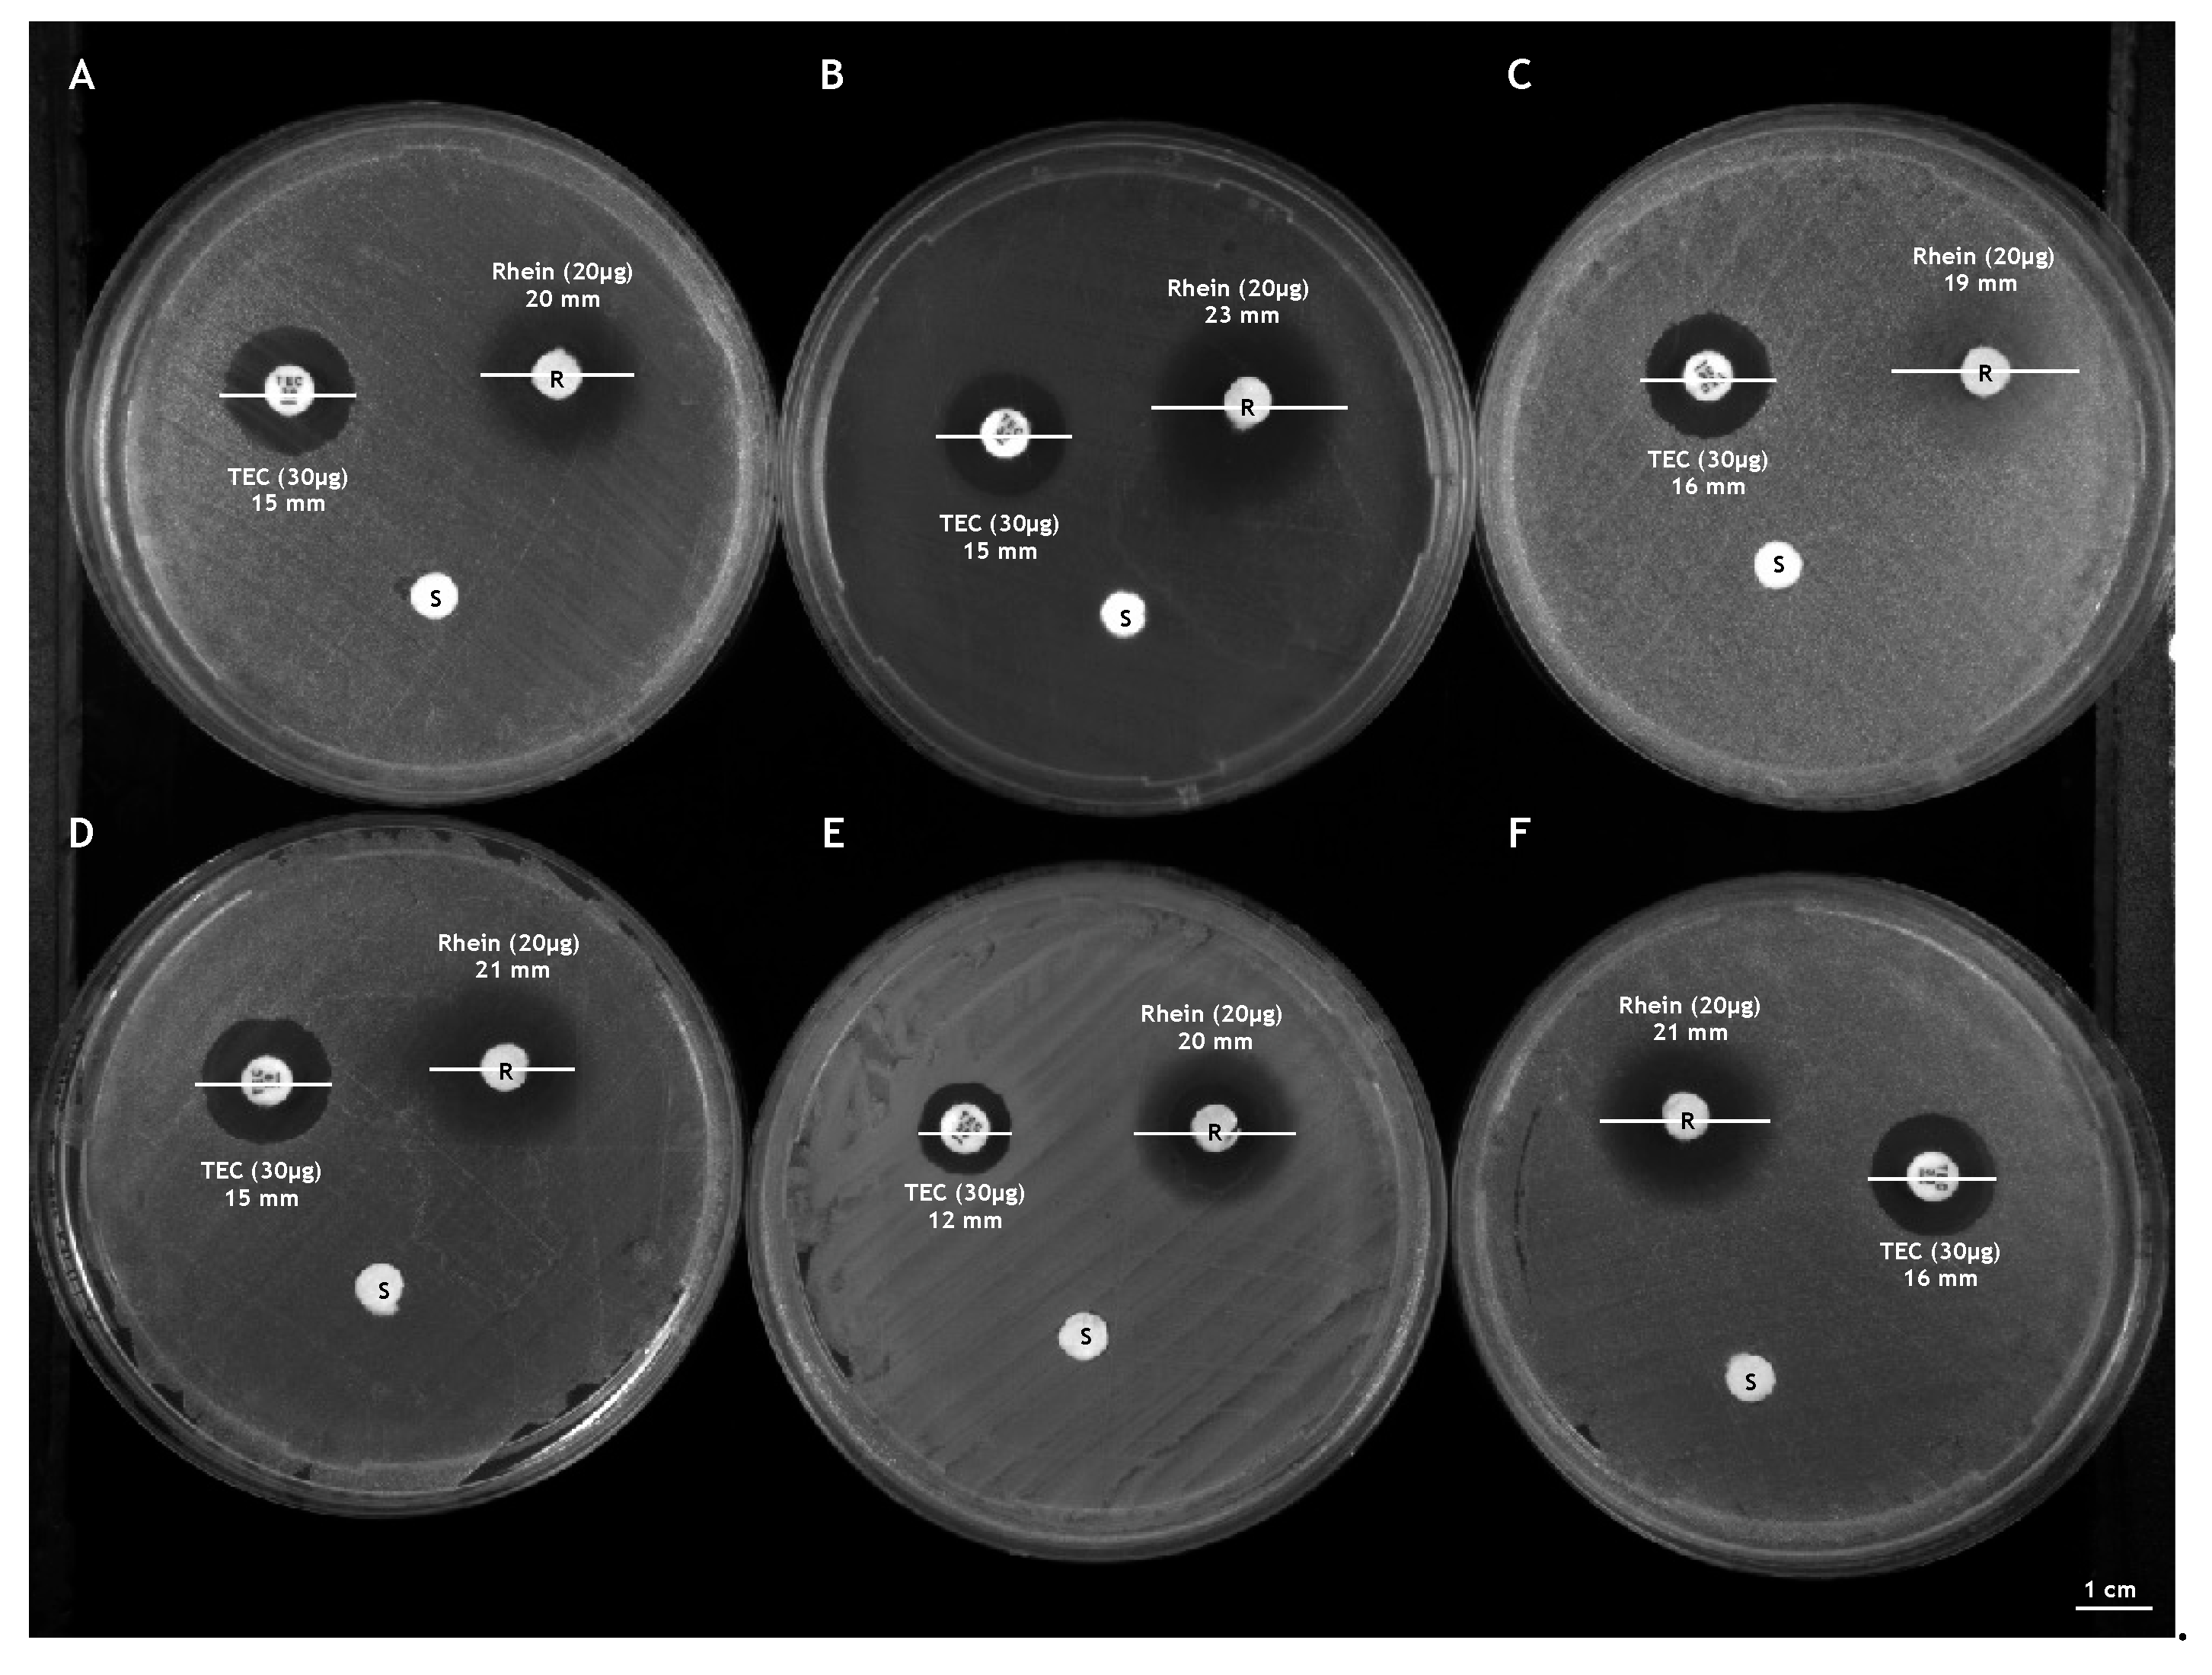

Anthraquinone Rhein Exhibits Antibacterial Activity against Staphylococcus aureus
Abstract
1. Introduction
2. Materials and Methods
2.1. Compound Preparation
2.2. Characterization of the Bacterial Strains
2.3. Bacterial Growth Conditions
2.4. Hemolysis Assay
2.5. Cell Cytotoxicity Assay
2.6. Kirby-Bauer Disk Diffusion Test
2.7. Antibacterial Susceptibility Assays
2.8. Bacterial Live/Dead Assay
2.9. Determination of the Selectivity Index (SI)
2.10. Time-Killing Assays
2.11. Measurement of S. aureus Hemolytic Activity
2.12. H2O2 Sensitivity Assay
2.13. Biofilm Degradation Assay
2.14. Statistic Analysis
3. Results
3.1. Cytotoxicity of Rhein
3.2. Effect of Rhein on the Growth of S. aureus
3.3. Rhein Effect on the Main Virulence Factors of S. aureus
3.4. Effect of Rhein on S. aureus Biofilm Biomass
4. Discussion
Author Contributions
Funding
Institutional Review Board Statement
Informed Consent Statement
Data Availability Statement
Conflicts of Interest
References
- Horn, C.M.; Kielian, T. Crosstalk between Staphylococcus aureus and Innate Immunity: Focus on Immunometabolism. Front. Immunol. 2021, 11, 621750. [Google Scholar] [CrossRef] [PubMed]
- de Jong, N.W.M.; van Kessel, K.P.M.; van Strijp, J.A.G. Immune Evasion by Staphylococcus aureus. Microbiol. Spectr. 2019, 7. [Google Scholar] [CrossRef] [PubMed]
- Raineri, E.J.M.; Altulea, D.; van Dijl, J.M. Staphylococcal trafficking and infection—From ‘nose to gut’ and back. FEMS Microbiol. Rev. 2021, 46, fuab041. [Google Scholar] [CrossRef] [PubMed]
- Tong, S.Y.C.; Davis, J.S.; Eichenberger, E.; Holland, T.L.; Fowler, V.G., Jr. Staphylococcus aureus Infections: Epidemiology, Pathophysiology, Clinical Manifestations, and Management. Clin. Microbiol. Rev. 2015, 28, 603–661. [Google Scholar] [CrossRef] [PubMed]
- Cheung, G.Y.C.; Bae, J.S.; Otto, M. Pathogenicity and virulence of Staphylococcus aureus. Virulence 2021, 12, 547–569. [Google Scholar] [CrossRef] [PubMed]
- Álvarez, A.; Fernández, L.; Gutiérrez, D.; Iglesias, B.; Rodríguez, A.; García, P. Methicillin-Resistant Staphylococcus aureus in Hospitals: Latest Trends and Treatments Based on Bacteriophages. J. Clin. Microbiol. 2019, 57, e01006-19. [Google Scholar] [CrossRef] [PubMed]
- Diekema, D.J.; Hsueh, P.-R.; Mendes, R.E.; Pfaller, M.A.; Rolston, K.V.; Sader, H.; Jones, R.N. The Microbiology of Bloodstream Infection: 20-Year Trends from the SENTRY Antimicrobial Surveillance Program. Antimicrob. Agents Chemother. 2019, 63, e00355-19. [Google Scholar] [CrossRef]
- Asokan, G.V.; Ramadhan, T.; Ahmed, E.; Sanad, H. WHO Global Priority Pathogens List: A Bibliometric Analysis of Medline-PubMed for Knowledge Mobilization to Infection Prevention and Control Practices in Bahrain. Oman Med. J. 2019, 34, 184–193. [Google Scholar] [CrossRef]
- Dweba, C.C.; Zishiri, O.T.; El Zowalaty, M. Methicillin-resistant Staphylococcus aureus: Livestock-associated, antimicrobial, and heavy metal resistance. Infect. Drug Resist. 2018, 11, 2497–2509. [Google Scholar] [CrossRef]
- Guo, Y.; Song, G.; Sun, M.; Wang, J.; Wang, Y. Prevalence and Therapies of Antibiotic-Resistance in Staphylococcus aureus. Front. Cell. Infect. Microbiol. 2020, 10, 107. [Google Scholar] [CrossRef]
- Terreni, M.; Taccani, M.; Pregnolato, M. New Antibiotics for Multidrug-Resistant Bacterial Strains: Latest Research Developments and Future Perspectives. Molecules 2021, 26, 2671. [Google Scholar] [CrossRef] [PubMed]
- Wu, Q.; Sabokroo, N.; Wang, Y.; Hashemian, M.; Karamollahi, S.; Kouhsari, E. Systematic review and meta-analysis of the epidemiology of vancomycin-resistance Staphylococcus aureus isolates. Antimicrob. Resist. Infect. Control 2021, 10, 1–13. [Google Scholar] [CrossRef] [PubMed]
- Shariati, A.; Dadashi, M.; Chegini, Z.; Van Belkum, A.; Mirzaii, M.; Khoramrooz, S.S.; Darban-Sarokhalil, D. The global prevalence of Daptomycin, Tigecycline, Quinupristin/Dalfopristin, and Linezolid-resistant Staphylococcus aureus and coagulase–negative staphylococci strains: A systematic review and meta-analysis. Antimicrob. Resist. Infect. Control 2020, 9, 1–20. [Google Scholar] [CrossRef] [PubMed]
- Bender, J.K.; Cattoir, V.; Hegstad, K.; Sadowy, E.; Coque, T.M.; Westh, H.; Hammerum, A.M.; Schaffer, K.; Burns, K.; Murchan, S.; et al. Update on prevalence and mechanisms of resistance to linezolid, tigecycline and daptomycin in enterococci in Europe: Towards a common nomenclature. Drug Resist. Updat. 2018, 40, 25–39. [Google Scholar] [CrossRef]
- Dell’Annunziata, F.; Folliero, V.; Giugliano, R.; De Filippis, A.; Santarcangelo, C.; Izzo, V.; Daglia, M.; Galdiero, M.; Arciola, C.; Franci, G. Gene Transfer Potential of Outer Membrane Vesicles of Gram-Negative Bacteria. Int. J. Mol. Sci. 2021, 22, 5985. [Google Scholar] [CrossRef] [PubMed]
- Vaou, N.; Stavropoulou, E.; Voidarou, C.; Tsigalou, C.; Bezirtzoglou, E. Towards Advances in Medicinal Plant Antimicrobial Activity: A Review Study on Challenges and Future Perspectives. Microorganisms 2021, 9, 2041. [Google Scholar] [CrossRef]
- Silver, L.L. Challenges of Antibacterial Discovery. Clin. Microbiol. Rev. 2011, 24, 71–109. [Google Scholar] [CrossRef]
- Joray, M.B.; González, M.L.; Palacios, S.M.; Carpinella, M.C. Antibacterial Activity of the Plant-Derived Compounds 23-Methyl-6-O-desmethylauricepyrone and (Z,Z)-5-(Trideca-4,7-dienyl)resorcinol and Their Synergy with Antibiotics against Methicillin-Susceptible and -Resistant Staphylococcus aureus. J. Agric. Food Chem. 2011, 59, 11534–11542. [Google Scholar] [CrossRef]
- Obiang-Obounou, B.W.; Kang, O.-H.; Choi, J.-G.; Keum, J.-H.; Kim, S.-B.; Mun, S.-H.; Shin, D.-W.; Kim, K.W.; Park, C.-B.; Kim, Y.-G.; et al. The mechanism of action of sanguinarine against methicillin-resistant Staphylococcus aureus. J. Toxicol. Sci. 2011, 36, 277–283. [Google Scholar] [CrossRef]
- Zhang, X.; Sun, X.; Wu, J.; Wu, Y.; Wang, Y.; Hu, X.; Wang, X. Berberine Damages the Cell Surface of Methicillin-Resistant Staphylococcus aureus. Front. Microbiol. 2020, 11, 621. [Google Scholar] [CrossRef]
- Wang, D.; Wang, X.-H.; Yu, X.; Cao, F.; Cai, X.; Chen, P.; Li, M.; Feng, Y.; Li, H.; Wang, X. Pharmacokinetics of Anthraquinones from Medicinal Plants. Front. Pharmacol. 2021, 12, 638993. [Google Scholar] [CrossRef] [PubMed]
- Zhou, Y.-X.; Xia, W.; Yue, W.; Peng, C.; Rahman, K.; Zhang, H. Rhein: A Review of Pharmacological Activities. Evid. Based Complement. Altern. Med. 2015, 2015, 578107. [Google Scholar] [CrossRef] [PubMed]
- Folliero, V.; Dell’Annunziata, F.; Roscetto, E.; Amato, A.; Gasparro, R.; Zannella, C.; Casolaro, V.; De Filippis, A.; Catania, M.R.; Franci, G.; et al. Rhein: A novel antibacterial compound against Streptococcus mutans infection. Microbiol. Res. 2022, 261, 127062. [Google Scholar] [CrossRef] [PubMed]
- Nguyen, A.T.; Kim, K.-Y. Rhein inhibits the growth of Propionibacterium acnes by blocking NADH dehydrogenase-2 activity. J. Med Microbiol. 2020, 69, 689–696. [Google Scholar] [CrossRef]
- Peerzada, Z.; Kanhed, A.M.; Desai, K.B. Effects of active compounds from Cassia fistula on quorum sensing mediated virulence and biofilm formation in Pseudomonas aeruginosa. RSC Adv. 2022, 12, 15196–15214. [Google Scholar] [CrossRef]
- Dell’Annunziata, F.; Martora, F.; Della Pepa, M.E.; Folliero, V.; Luongo, L.; Bocelli, S.; Guida, F.; Mascolo, P.; Campobasso, C.P.; Maione, S.; et al. Postmortem interval assessment by MALDI-TOF mass spectrometry analysis in murine cadavers. J. Appl. Microbiol. 2021, 132, 707–714. [Google Scholar] [CrossRef]
- Pironti, C.; Dell’Annunziata, F.; Giugliano, R.; Folliero, V.; Galdiero, M.; Ricciardi, M.; Motta, O.; Proto, A.; Franci, G. Comparative analysis of peracetic acid (PAA) and permaleic acid (PMA) in disinfection processes. Sci. Total Environ. 2021, 797, 149206. [Google Scholar] [CrossRef]
- Zheng, X.; Fang, R.; Wang, C.; Tian, X.; Lin, J.; Zeng, W.; Zhou, T.; Xu, C. Resistance Profiles and Biological Characteristics of Rifampicin-Resistant Staphylococcus aureus Small-Colony Variants. Infect. Drug Resist. 2021, 14, 1527–1536. [Google Scholar] [CrossRef]
- Taylor, T.A.; Unakal, C.G. Staphylococcus aureus. In StatPearls; StatPearls Publishing: Treasure Island, FL, USA, 2022. [Google Scholar]
- Lade, H.; Kim, J.-S. Bacterial Targets of Antibiotics in Methicillin-Resistant Staphylococcus aureus. Antibiotics 2021, 10, 398. [Google Scholar] [CrossRef]
- Saha, M.; Sarkar, A. Review on Multiple Facets of Drug Resistance: A Rising Challenge in the 21st Century. J. Xenobiotics 2021, 11, 197–214. [Google Scholar] [CrossRef]
- Schneider, Y. Bacterial Natural Product Drug Discovery for New Antibiotics: Strategies for Tackling the Problem of Antibiotic Resistance by Efficient Bioprospecting. Antibiotics 2021, 10, 842. [Google Scholar] [CrossRef] [PubMed]
- Yu, L.; Xiang, H.; Fan, J.; Wang, D.; Yang, F.; Guo, N.; Jin, Q.; Deng, X. Global transcriptional response of Staphylococcus aureus to Rhein, a Natural Plant Product. J. Biotechnol. 2008, 135, 304–308. [Google Scholar] [CrossRef] [PubMed]
- Food Research and Technology, the Hershey Company, PA, USA; Wu, X. Antibacterial activities of rhubarb extract and the bioactive compounds against Salmonella. Int. J. Nutr. Sci. Food Technol. 2015, 1, 1–9. [Google Scholar] [CrossRef][Green Version]
- Thammavongsa, V.; Kim, H.K.; Missiakas, D.; Schneewind, O. Staphylococcal manipulation of host immune responses. Nat. Rev. Genet. 2015, 13, 529–543. [Google Scholar] [CrossRef] [PubMed]
- Tam, K.; Torres, V.J. Staphylococcus aureus Secreted Toxins and Extracellular Enzymes. Microbiol. Spectr. 2019, 7. [Google Scholar] [CrossRef] [PubMed]
- Das, D.; Bishayi, B. Contribution of Catalase and Superoxide Dismutase to the Intracellular Survival of Clinical Isolates of Staphylococcus aureus in Murine Macrophages. Indian J. Microbiol. 2010, 50, 375–384. [Google Scholar] [CrossRef] [PubMed]
- Singh, V.; Phukan, U.J. Interaction of host and Staphylococcus aureus protease-system regulates virulence and pathogenicity. Med. Microbiol. Immunol. 2018, 208, 585–607. [Google Scholar] [CrossRef]
- Folliero, V.; Dell’Annunziata, F.; Roscetto, E.; Cammarota, M.; De Filippis, A.; Schiraldi, C.; Catania, M.R.; Casolaro, V.; Perrella, A.; Galdiero, M.; et al. Niclosamide as a Repurposing Drug against Corynebacterium striatum Multidrug-Resistant Infections. Antibiotics 2022, 11, 651. [Google Scholar] [CrossRef]
- Marshall, J.S.; Warrington, R.; Watson, W.; Kim, H.L. An introduction to immunology and immunopathology. Allergy Asthma Clin. Immunol. 2018, 14, 1–10. [Google Scholar] [CrossRef]
- Hotinger, J.A.; Morris, S.T.; May, A.E. The Case against Antibiotics and for Anti-Virulence Therapeutics. Microorganisms 2021, 9, 2049. [Google Scholar] [CrossRef]
- Tomlinson, K.L.; Prince, A.S.; Lung, T.W.F. Immunometabolites Drive Bacterial Adaptation to the Airway. Front. Immunol. 2021, 12, 790574. [Google Scholar] [CrossRef] [PubMed]
- Muhammad, M.H.; Idris, A.L.; Fan, X.; Guo, Y.; Yu, Y.; Jin, X.; Qiu, J.; Guan, X.; Huang, T. Beyond Risk: Bacterial Biofilms and Their Regulating Approaches. Front. Microbiol. 2020, 11, 928. [Google Scholar] [CrossRef] [PubMed]
- Khatoon, Z.; McTiernan, C.D.; Suuronen, E.J.; Mah, T.-F.; Alarcon, E.I. Bacterial biofilm formation on implantable devices and approaches to its treatment and prevention. Heliyon 2018, 4, e01067. [Google Scholar] [CrossRef] [PubMed]
- Kim, D.; Kim, K.-Y. Combinatorial treatment of sophoraflavanone G and rhein with ampicillin, oxacillin, or oxytetracycline synergistically increased antibacterial activity against oral bacteria. Rev. Med Microbiol. 2021, 32, 211–218. [Google Scholar] [CrossRef]
- Sena, F.V.; Sousa, F.M.; Oliveira, A.S.F.; Soares, C.M.; Catarino, T.; Pereira, M.M. Regulation of the mechanism of Type-II NADH: Quinone oxidoreductase from S. aureus. Redox Biol. 2018, 16, 209–214. [Google Scholar] [CrossRef]
- Lencina, M.; Franza, T.; Sullivan, M.J.; Ulett, G.C.; Ipe, D.S.; Gaudu, P.; Gennis, R.B.; Schurig-Briccio, L.A. Type 2 NADH Dehydrogenase Is the Only Point of Entry for Electrons into the Streptococcus agalactiae Respiratory Chain and Is a Potential Drug Target. mBio 2018, 9, e01034-18. [Google Scholar] [CrossRef]
- Goodwine, J.; Gil, J.; Doiron, A.; Valdes, J.; Solis, M.; Higa, A.; Davis, S.; Sauer, K. Pyruvate-depleting conditions induce biofilm dispersion and enhance the efficacy of antibiotics in killing biofilms in vitro and in vivo. Sci. Rep. 2019, 9, 3763. [Google Scholar] [CrossRef]
- Schurig-Briccio, L.A.; Solorzano, P.K.P.; Lencina, A.M.; Radin, J.N.; Chen, G.Y.; Sauer, J.; Kehl-Fie, T.E.; Gennis, R.B. Role of respiratory NADH oxidation in the regulation of Staphylococcus aureus virulence. EMBO Rep. 2020, 21, e45832. [Google Scholar] [CrossRef]

| Bacterial Species | Strain Code | Resistance Phenotype | Anatomical District |
|---|---|---|---|
| S. aureus | ATCC 6538 | Multisensitive | Standard strain |
| S. aureus | ATCC 1167 | Multisensitive | Standard strain |
| S. aureus | C1 | Multisensitive | Eye |
| S. aureus | C2 | Beta-lactamase producer | Bladder |
| S. aureus | C3 | Constitutive resistance to macrolides | Skin |
| S. aureus | C4 | Quinolone resistance | Pharynx |
| S. aureus | C5 | Methicillin resistance | Blood |
Publisher’s Note: MDPI stays neutral with regard to jurisdictional claims in published maps and institutional affiliations. |
© 2022 by the authors. Licensee MDPI, Basel, Switzerland. This article is an open access article distributed under the terms and conditions of the Creative Commons Attribution (CC BY) license (https://creativecommons.org/licenses/by/4.0/).
Share and Cite
Dell’Annunziata, F.; Folliero, V.; Palma, F.; Crudele, V.; Finamore, E.; Sanna, G.; Manzin, A.; De Filippis, A.; Galdiero, M.; Franci, G. Anthraquinone Rhein Exhibits Antibacterial Activity against Staphylococcus aureus. Appl. Sci. 2022, 12, 8691. https://doi.org/10.3390/app12178691
Dell’Annunziata F, Folliero V, Palma F, Crudele V, Finamore E, Sanna G, Manzin A, De Filippis A, Galdiero M, Franci G. Anthraquinone Rhein Exhibits Antibacterial Activity against Staphylococcus aureus. Applied Sciences. 2022; 12(17):8691. https://doi.org/10.3390/app12178691
Chicago/Turabian StyleDell’Annunziata, Federica, Veronica Folliero, Francesca Palma, Valeria Crudele, Emiliana Finamore, Giuseppina Sanna, Aldo Manzin, Anna De Filippis, Massimiliano Galdiero, and Gianluigi Franci. 2022. "Anthraquinone Rhein Exhibits Antibacterial Activity against Staphylococcus aureus" Applied Sciences 12, no. 17: 8691. https://doi.org/10.3390/app12178691
APA StyleDell’Annunziata, F., Folliero, V., Palma, F., Crudele, V., Finamore, E., Sanna, G., Manzin, A., De Filippis, A., Galdiero, M., & Franci, G. (2022). Anthraquinone Rhein Exhibits Antibacterial Activity against Staphylococcus aureus. Applied Sciences, 12(17), 8691. https://doi.org/10.3390/app12178691










